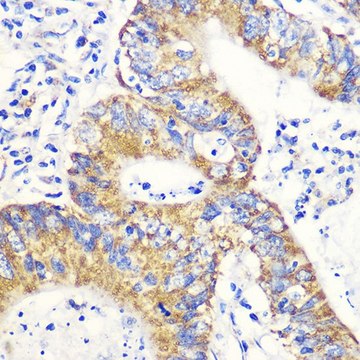
Anti-NRF2 antibody produced in rabbit

Anti-NRF2 antibody produced in rabbit
Synonyme(s):
HEBP1, NF-E2 related factor 2, NF2L2, NFE2-related factor 2, NFE2L2
Products
Catégorie de produit
Marque
Source biologique
Clonalité
Alias de gène
Forme physique
Forme d'anticorps
Zone de recherche
Conjugué
Niveau de qualité
Modification post-traductionnelle
Espèces réactives
Technique
Showing 1-2 of 2
Comparer
Numéro du produit
Description
Tarif